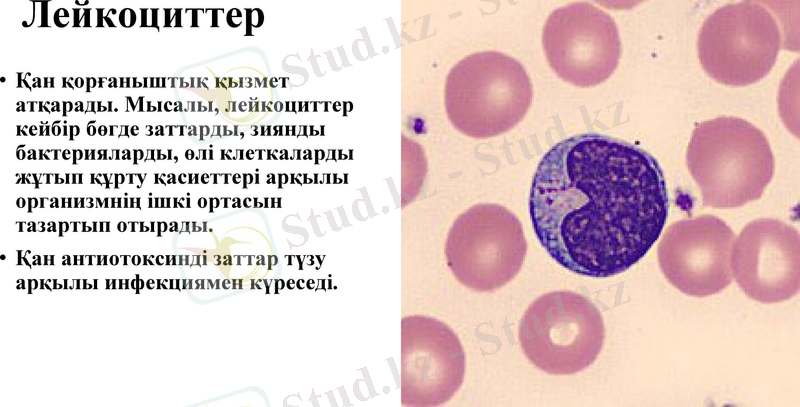
Slide 15

Қанның құрамы, қызметтері және қан топтарын анықтау



Қан топтарын анықтау
Дайындаған: Таштамирова Зухра

Жоспары


Қанның құрамы
Ағзаның ішкі ортасына қан, ұлпа сұйықтығы, лимфа жатады.
Қанның қызметі:
адам ағзасында қан әрбір мүшені, дененің әрбір жасушасын бірімен-бірін өзара байланыстырады;
оттегін өкпеден ұлпаларға жеткізіп, көмірқышқыл газынан тазарта-ды;
қорек заттарды асқорыту мүшелерінен ұлпаларға жеткізеді;
ағзаның соңғы қажетсіз өнімдерін бүйрекке және т. б. мүшелерге тасымалдайды;
дене температурасының тұрақтылығын сақтайды;
ағзаны зиянды микробтардан қорғайды;
ішкі секреция бездерінен бөлінетін гормондарды тасымалдайды;
жасушаларда қышқылдың, судың деңгейін реттейді;
қорғаныштық қызмет атқарады (қанды ұйыта алады) .

Қан газ тасымалдайды
Қоректік заттар,
метаболиттер,
зат алмасудың
соңғы өнімдері
гормон

Қан-қоректік және қорғаныш қызметтер атқаратын сұйық дәнекер ұлпа.
Қан-бұл сұйық зат, дене салмағының он екіден бір бөлігін құрайды.
Орташа алғанда ересек адамда 5-5, 5л қан болады.
Қан екі
құрылымнан
тұрады:
Қан клеткалары
40-45%
Қан плазмасы
55-60%

Қанның құрамы
қан
сарысуы
қан
клеткасы
қан
плазмасы
қан

ЭРИТРОЦИТТЕР
1673ж.
Левенгук ашқан
Лейкоциттерге
қарағанда
500-1000 есе көп.
организмде тотығу
процесіне қажетті оттегін
тартып, көмір қышқылын
организмнен шығару
қызметін атқарады.
Оттегінің таралуы
, эритроциттің негізін
құрайтын тыныс алу
пигменті - гемоглобин
арқылы орындалады.
Сүтқорек
тілерде
ядросы
болмайды.


Формасы
өзгермелі
Иілгіш және жазық
түрі кездеседі
Серпімді созылып,
ұзарады
Кішкене түтік
капиллярдан
өткенде өзгереді

Ерлерде -5млн
Әйелдерде -4, 5млн
Адам эритроцит көлемі- 125мкм
диаметрі- 7, 5 мкм, көлденеңінен 1, 9-2, 5мкм
Адамда 2 литр эритроцит бар, 25 трилион
Нәрестеде -6-7 млн
Қарттарда-
қалыптан көп
1мм қандағы эритроцит саны
3
Гемоглобин
азаюына
байланысты
10-11 жаста
қалпына келеді

Эритроцит
60 % су
40 % тығыз зат
95 % гемоглобин
5 % эритроциттің
клетка заты
темір
белок

Әртүрлі жануарлар эритроцитері
Ең ұсақ эритроцит
ешкінікі-4 мкм,
есесіне 1мм 14, 5млн
Бақада
23-16 мкм

Қан плазмасының құрамы
Плазма
90 %
Су
7%
белок
3 %
Органикалық
және бейорганикалық
қосылыстыр
Альбумин,
глобулин,
фибриноген
Амин қышқылдары,
майлар, глюкоза,
минералды тұздар,
гормондар,
ферменттер
Лейкоциттер
Қан қорғаныштық қызмет атқарады. Мысалы, лейкоциттер кейбір бөгде заттарды, зиянды бактерияларды, өлі клеткаларды жұтып құрту қасиеттері арқылы организмнің ішкі ортасын тазартып отырады.
Қан антиотоксинді заттар түзу арқылы инфекциямен күреседі.

Лейкоцит
1мм 6-8 мың
3
1 лейкоцитке
600-700 эритроцит
1мм 3-10 мың
3
Тамақтану,
жұмыс істеу кезінде




Нейтрофил
Эозинофил
Базофил
Лимфоцит
Моноциты
Тромбоцит
Эритроцит

Түйіршіктері жоқ лейкоциттер -агранулоциттер деп аталады.
Лимфоциттердің ядролары сегменттелмеген.
Олардың мөлшері ересек адамдарда 24-30% аралығында.
Организмде лейкоциттердің, үлкен, орташа және кішкене түрлері кездеседі.
Қалыпты жағдайда лимфоциттер тек лимфалық қан жасау мүшелерінде жиналып жатады.
Лимфоциттердің клетка органоидтары жақсы жетілген

Тромбоциттер
Тромбоциттер олар адамда клетка емес, клетканың бөліктері сияқты, сондықтан қан пластинкалары деп аталады.
Тромбоциттердің клетка емес екендігі анық, бірақ пайда болу жолы белгісіз, пішіні тұрақсыз, ішкі ортаның жағдайына сезімтал келеді.
Адамның қан пластинкасы өте кішкене 2-3 мкм, оның есесіне олардың саны өте көп 1мм-де 15-3

ҚАН ПЛАСТИНКАСЫ

қан ұюы


Адамның қан топтары
«1930 жылы австралиялық ғалым Карл Ландшейнер қан топтарын ашқаны үшін Нобель сыйлығын алған».
Донор-өз еркімен қан беретін адам.
Реципиент-донордан қан алатын адам
Агглютинация-эритроциттердің бірігіп қалуы.
Адамдардың 85 % қанында резус-фактор бар, оларды оң резус-фактор деп атайды.
Ал 15 %-ында резус фактор жоқ, оларды теріс резус дейді.
Қан құйғанда резус-фактор ескерілуі тиіс.

Дүниежүзі халқындағы қан топтарының таралуы
1 топ - 40 %
2 топ - 40 %
3 топ - 10-14 %
4 топ - 6 %
Rh (+) Rh (-)



Қан топтары
0 (I) қан тобы

Қан тобы
А (II) қан тобы

Қан топтары
B (III) қан тобы

Қан топтары
AB (IV) қан тобы

Қан тобын анықтау
Қан тобын цоликлондар Анти А және Анти В көмегімен анықтау
Құрғақ пробиркаға венадан қан алып, тыныштыққа қояды сарысу бөліну үшін 20-30 минутқа.
Ақ пластинкаға (планшетке) солдан оңға қарай : анти -А, анти - В, және анти - Д цоликлондарын тамызамыз. Жоғарғы жағына қан тобын анықтайтын адамның фамилиясы мен инициалдарын жазады.
Анти - А, Анти - В, Анти- Д цоликлондарын үлкен тамшымен (0, 01 мл) тамызады.
Антитела тамшылары жанына зерттейтін қаннан кіші тамшыдан (0, 01- 0, 03) құямыз да араластырамыз.

Пластинканы 3 минут шайқап тұрып бақылаймыз, цоликлондар мен эритроциттер агглютинациясы бастапқы 3 - 5 секундта байқалады.
- Іс жүргізу
- Автоматтандыру, Техника
- Алғашқы әскери дайындық
- Астрономия
- Ауыл шаруашылығы
- Банк ісі
- Бизнесті бағалау
- Биология
- Бухгалтерлік іс
- Валеология
- Ветеринария
- География
- Геология, Геофизика, Геодезия
- Дін
- Ет, сүт, шарап өнімдері
- Жалпы тарих
- Жер кадастрі, Жылжымайтын мүлік
- Журналистика
- Информатика
- Кеден ісі
- Маркетинг
- Математика, Геометрия
- Медицина
- Мемлекеттік басқару
- Менеджмент
- Мұнай, Газ
- Мұрағат ісі
- Мәдениеттану
- ОБЖ (Основы безопасности жизнедеятельности)
- Педагогика
- Полиграфия
- Психология
- Салық
- Саясаттану
- Сақтандыру
- Сертификаттау, стандарттау
- Социология, Демография
- Спорт
- Статистика
- Тілтану, Филология
- Тарихи тұлғалар
- Тау-кен ісі
- Транспорт
- Туризм
- Физика
- Философия
- Халықаралық қатынастар
- Химия
- Экология, Қоршаған ортаны қорғау
- Экономика
- Экономикалық география
- Электротехника
- Қазақстан тарихы
- Қаржы
- Құрылыс
- Құқық, Криминалистика
- Әдебиет
- Өнер, музыка
- Өнеркәсіп, Өндіріс
Қазақ тілінде жазылған рефераттар, курстық жұмыстар, дипломдық жұмыстар бойынша біздің қор #1 болып табылады.



Ақпарат
Қосымша
Email: info@stud.kz